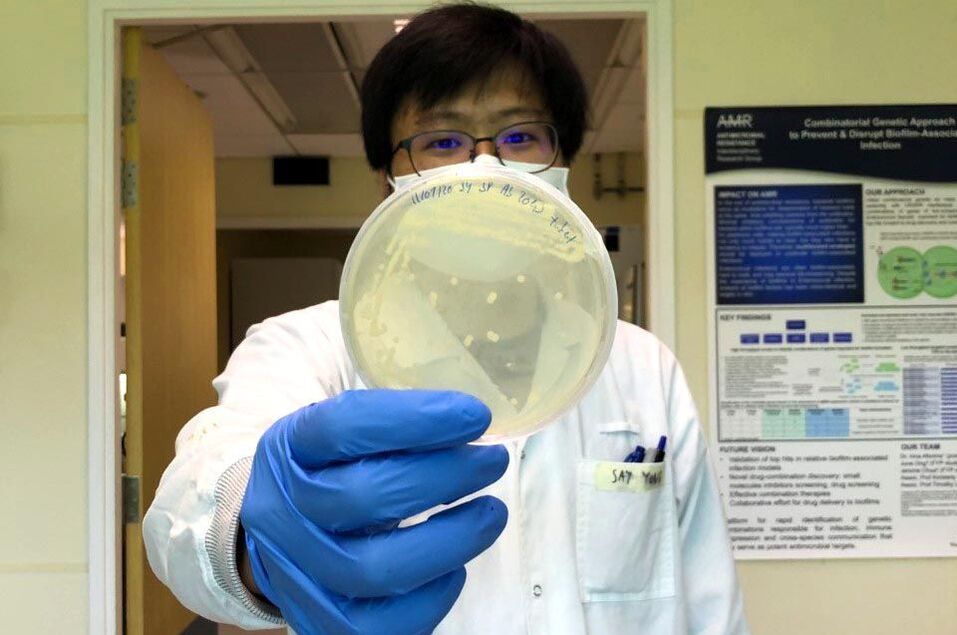
Healthcaretoday, antibiotic resistance, bacteria, Singapore-MIT Alliance for Research and Technology, SMART, hydrogen sulfide, drug resistance, antibiotic tolerance, antimicrobial resistance,

GLOBAL HEALTH HEADLINES
From lunch tray to lifelong health: WHO sets global standards for school meals
Global guidance highlights how healthier school meals shape children’s nutrition, learning, and futures
|
India contains Nipah virus outbreak as Asian nations increase health screenings
Regional surveillance intensifies following confirmed cases and precautionary travel measures
|
Australia’s ‘Super-K’ flu strain sparks record global influenza outbreaks
Fast-spreading H3N2 variant emerges after prolonged flu season, raising global surveillance concerns
|
Global study reveals massive hidden health burden from violence against women and children
Intimate partner violence drives severe anxiety, self-harm, and deadly outcomes
|
San Francisco sues food giants for marketing harmful ultra-processed productsOne of the first US government lawsuits targets food giants including Kraft Heinz, Mondelez International, and Coca-Cola
|
INTERNATIONAL POLICY & HEALTHCARE SYSTEMS
Opinion - Upholding biological truth: Supporting Trump's executive order on gender recognition
The positive implications for Malaysia's social landscape
|
The US election will be a turning point for healthcare in 2020 |